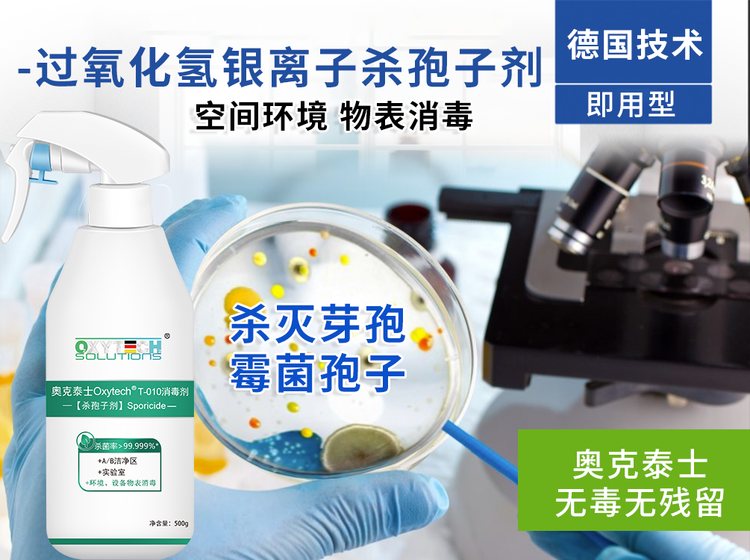

|
Contact Us
Follow0
Handong hafeng biotechnic co. Ltd企业会员No.1Year
ProfileUncertified
DepositUnpaid
|

价格:向品在花生壳b2b外贸信息平台的展示标价,县体的成文价情可能因向品参加活动考情况发生变化,也可能随者购买数量不同或所选规信不同而发生变化,如用户与向家线下达成协议,以线下协议的结算价格为准,如用户在花生壳b2b外贸信息平台上完成线上购买,则最终以订单结算页价格为准。
抢购价:商品参与营销活动的活动价格,也可能随着购买数量不同或所选规格不同而发生变化,最终以订单结算页价格为准。
特别提示:商品详情页中(含主图)以文字或者图片形式标注的抢购价等价格可能是在特定活动时段下的价格,商品的具体价格以订单结算页价格为准或言是您与商家联系后协商达成的实际成交价格为准;如您发现活动商品价格或活动信息有异常,建议购买前先咨询商家。